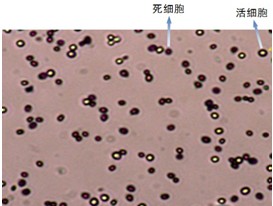

艾力特Counstar酵母/藻類自動計數儀新品免費試用
瀏覽次數:11048 發布日期:2013-12-18
來源:本站 本站原創,轉載請注明出處
Counstar酵母/藻類自動計數儀新品上市
--免費試用火熱進行中
簡單、快速、準確、全面
為了滿足客戶的需求,經過長期的研究、開發、測試與完善,Countstar自動酵母計數儀和Countstar自動藻類計數儀終于正式與大家見面了,目前兩款產品均可免費試用,歡迎各位新老客戶前來洽談合作!
在線提交:試用申請

Countstar自動酵母計數儀
是一款結合了智能圖像識別技術和美蘭染色方法,對酵母進行濃度檢測與死亡率分析的離線檢測儀器,其獨特的智能圖像識別與標定技術使檢測結果清晰可見。
在延續Countstar 自動細胞計數儀各項優良傳統的基礎上,專門針對酵母細胞的特點進行了研發制造,Countstar酵
母自動計數儀對于啤酒企業生產與研發的貢獻在于:
通過準確穩定的酵母計數,與流量計結合起來,實現酵母添加量的準確控制,從而減少發酵的批間差異,維持發酵的一致性,穩定發酵工藝,提高啤酒品質;并通過準確的濃度、死亡率的檢測來提高酵母菌的利用率,降低發酵成本。實現起來也非常簡單,定期將所需檢測的酵母樣本添加到計數板中,電腦中的軟件在10秒左右的時間會自動給出相應結果,簡單可靠,的確是很棒的工具!
|
技術參數 |
|
濃度范圍:5×104—3×107/ml; 樣本體積:20ul 測量時間:5-20s 數據輸出格式:JPG、PDF、EXCEL 直徑范圍:2-180 um(需活率判斷的直徑需大于6um) USB版本:USB2.0 操作系統:windows XP、windows 7、windows 8 |
Countstar 自動藻類計數儀
是一款整合了先進的光學成像與智能圖像識別技術,為了準確檢測藻類濃度而開發的專業級藻類自動計數儀,其軟件系統集強大的分析功能和數據庫管理功能于一體。
|
 A 筒柱藻Countstar Algae檢測結果
|
 B 鹽藻Countstar Algae檢測結果
|
可針對多種形狀球型、橢圓型、管狀、絲狀、鏈狀等不同形狀的藻類進行計數分析
無論純培養的單細胞藻類還是混合培養的多藻類樣本,Countstar自動藻類計數儀均可提供準確的,具有高重復性的計數結果。Countstar自動藻類計數儀可自動計算藻類的濃度、長軸和短軸并可生成反映藻類生長狀況的藻類生長曲線,也可選擇根據復雜樣本中藻類大小或形態特征來篩選目標藻類進行分類計數。

可針對稍復雜樣本中所有藻類進行計數,也可根據不同形態與大小,對混合藻類進行篩選計數
|
技術參數 |
|
檢測參數:濃度、軸長、結團率、生長曲線
濃度范圍:1x104-3x107/ml
大小范圍:2-180um
樣品體積:20μL
測量時間:20秒以內:5個
數據輸出格式:JPG、PDF、EXCEL |